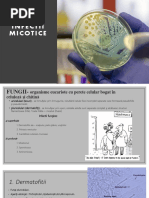

0% au considerat acest document util (0 voturi)
336 vizualizări4 paginiOnicomicoza
Documentul prezintă informații despre onicomicoză, o infecție micotică a unghiilor cauzată de ciuperci sau dermatofiți. Sunt descrise cauzele, formele clinice, diagnosticul și tratamentul acestei afecțiuni frecvente.
Încărcat de
silviaDrepturi de autor
© © All Rights Reserved
Respectăm cu strictețe drepturile privind conținutul. Dacă suspectați că acesta este conținutul dumneavoastră, reclamați-l aici.
Formate disponibile
Descărcați ca DOC, PDF, TXT sau citiți online pe Scribd
0% au considerat acest document util (0 voturi)
336 vizualizări4 paginiOnicomicoza
Documentul prezintă informații despre onicomicoză, o infecție micotică a unghiilor cauzată de ciuperci sau dermatofiți. Sunt descrise cauzele, formele clinice, diagnosticul și tratamentul acestei afecțiuni frecvente.
Încărcat de
silviaDrepturi de autor
© © All Rights Reserved
Respectăm cu strictețe drepturile privind conținutul. Dacă suspectați că acesta este conținutul dumneavoastră, reclamați-l aici.
Formate disponibile
Descărcați ca DOC, PDF, TXT sau citiți online pe Scribd